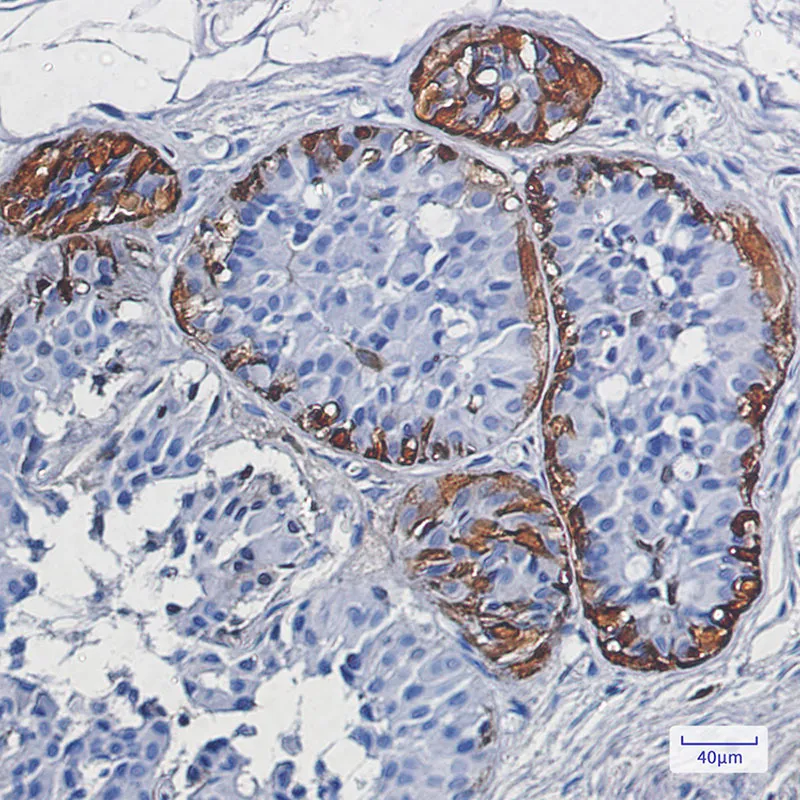
Immunohistochemistry analysis of paraffin-embedded Human breast cancer using S100 beta antibody. High-pressure and temperature Sodium Citrate pH 6.0 was used for antigen retrieval.

S100B Rabbit Monoclonal Antibody
| Cat Number: | MABN02563 |
|---|---|
| Conjugate: | Unconjugated |
| Size: | 100ul |
| Concentration: | 1mg/ml |
| Host: | Rabbit |
| Isotype: | IgG |
| Immunogen: | A synthetic peptide of human S100B |
| Reactivity: | Human,Rat |
| Applications: | WB 1:500-1:1000,IHC 1:50-1:100,IP 1:20-1:50 |
| Molecular: | 11 kDa |
| Purification: | Affinity purification |
| Synonyms: | NEF; Protein S100 B; Protein S100-B; S 100 calcium binding protein beta chain; S 100 protein beta chain; S-100 protein beta chain; S-100 protein subunit beta; S100; S100 calcium binding protein beta (neural); S100 calcium-binding protein B; S100 protein beta chain; S100B; S100B_HUMAN; S100beta. |
| Background: | Despite their relatively small size (8-12 kDa) and uncomplicated architecture, S100 proteins regulate a variety of cellular processes such as cell growth and motility, cell cycle progression, transcription, and differentiation. To date, 25 members have been identified, including S100A1-S100A18, trichohyalin, filaggrin, repetin, S100P, and S100Z, making it the largest group in the EF-hand, calcium-binding protein family. |
| Form: | liquid |
| Buffer: | 50mM Tris-Glycine(pH 7.4), 0.15M NaCl, 40% Glycerol, 0.01% Sodium azide and 0.05% protective protein |
| Storage: | Store at 4°C short term. Aliquot and store at -20°C long term. Avoid freeze/thaw cycles. |

Western blot analysis of S100 beta in rat Brain lysates using S100B antibody.

Western blot analysis of S100 beta in rat Brain lysates using S100 beta antibody.
Immunohistochemistry analysis of paraffin-embedded Human breast cancer using S100 beta antibody. High-pressure and temperature Sodium Citrate pH 6.0 was used for antigen retrieval.
